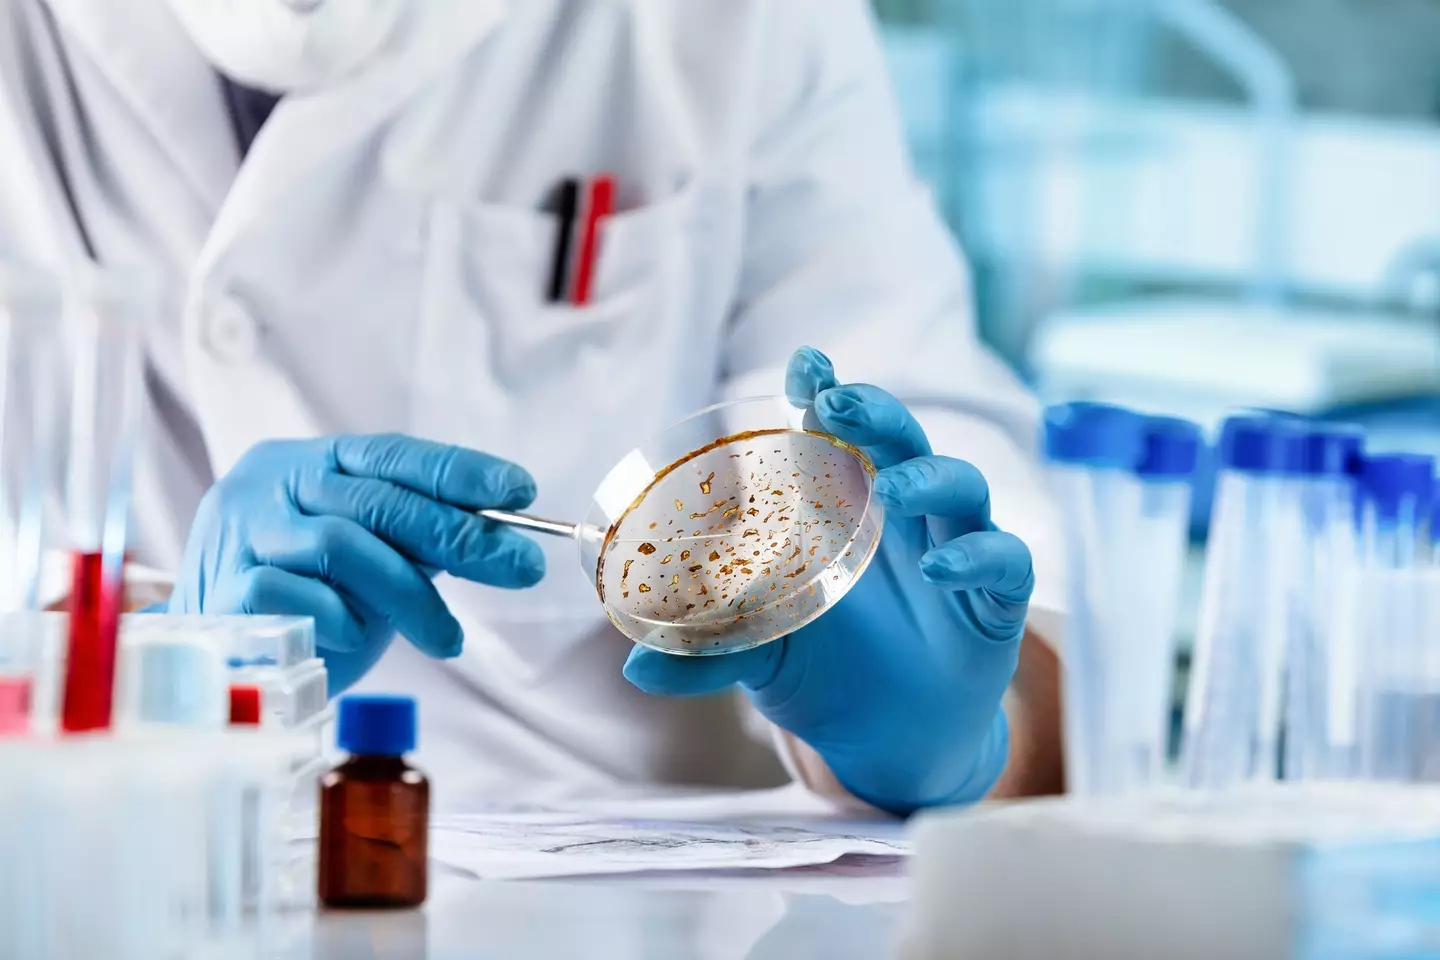

A species of black fungus at the site of the Chernoyl disaster has mutated to 'feed' on nuclear radiation that would be lethal to most life forms.
In the early hours of April 26, 1986, one of the most devastating nuclear disasters in history struck the Chernobyl Nuclear Power Plant in Pripyat, Ukraine.
Chernobyl's Reactor 4 experienced a critical meltdown, which resulted in a number of explosions, raging fires and a catastrophic spread of radiation across surrounding areas.
Dozens of people were killed in the direct aftermath of the Chernobyl disaster, with thousands later dying due to radiation-related causes in the years that followed.
Advert
The disaster happened more almost four decades ago, but the 20-mile radius surrounding the power plant - known as the exclusion zone - remains one of the most contaminated places on Earth and will not be habitable for about 20,000 years due to the long-lasting effects of radiation.
However, while the nuclear radiation would be harmful to most life forms, a black fungus found at the site has adapted to 'feeding' off it.

Radiation-eating fungus: how does it work?
Cladosporium sphaerospermum is a highly resilient species of black fungus that has been observed growing on the walls of Chernobyl's Reactor 4 since the disaster.
Advert
Scientists have found that the fungus has mutated to use nuclear radiation as a source of energy in a similar way to how plants get energy from the sun.
It gets its radiation-eating power from melanin - the pigment that gives humans their skin color and acts as a shield against harmful UV rays.
But, the fungus 'does more than shield: it facilitates energy productions,' according to Rutgers University evolutionary biologist Scott Travers. This process, in which melanin absorbs radiation and converts it into chemical energy, is known as radiosynthesis.
Fungus could hold the key to better space travel
Now, scientists hope they may be able to harness this process to create radiation shields that can protect astronauts during deep space missions.
Advert
Harsh radioactive conditions in space is a major hurdle in long-term missions, with astronauts being exposed to the equivalent of one year's exposure on Earth in just one week on the International Space Station (ISS).
And, according to the European Space Agency (ESA), an astronaut on a mission to Mars could be exposed to doses of radiation up to 700 times higher than on our planet.
Researchers aboard the ISS have studied cladosporium sphaerospermum's ability to reduce the effect of harmful radiation in an environment similar to Mars' surface.
They found that that the fungus blocked and absorbed 84 percent of the space radiation. The fungus also showed significant growth over a 26-day period, suggesting its ability to perform radiosynthesis could extend to space environments.
Topics: World News, Science, Chernobyl